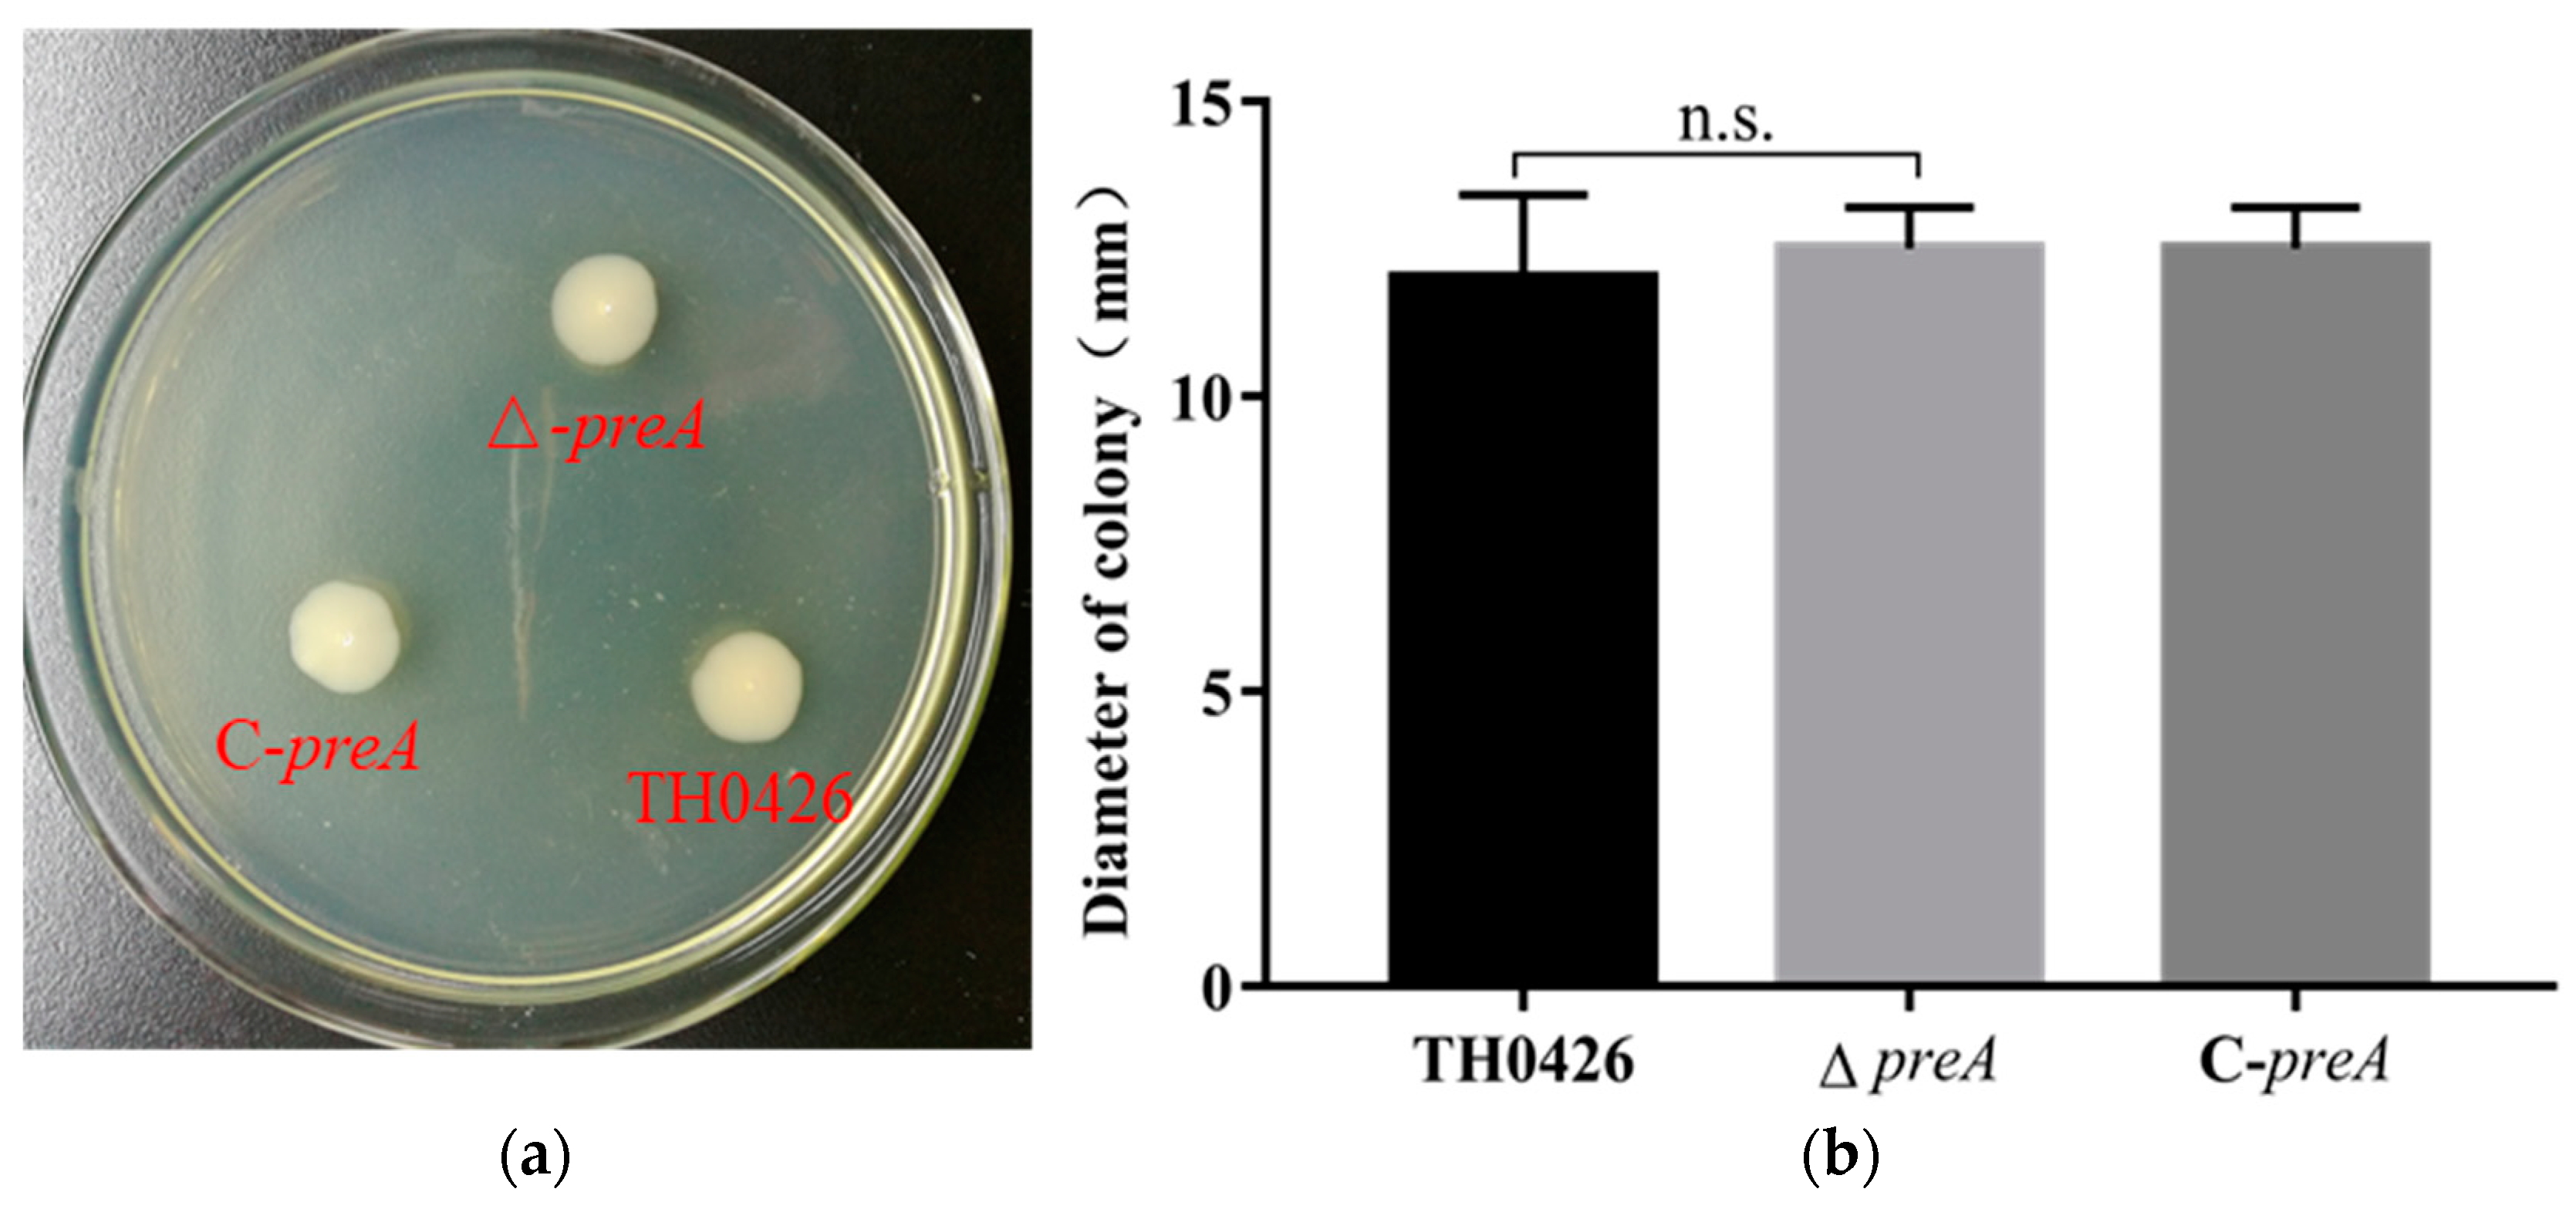

Functional Analysis of preA in Aeromonas veronii TH0426 Reveals a Key Role in the Regulation of Virulence and Resistance to Oxidative Stress
Abstract
1. Introduction
2. Results
2.1. Construction and Characterization of the Mutant Strain ∆preA and Complemented Strain C-preA
2.2. The preA Gene is not Involved in Growth Regulation
2.3. The Contribution of the preA Gene to Motility
2.4. preA Mutation does not Change the Biofilm Formation Ability of TH0426
2.5. LD50 and Virulence
2.6. The Adhesion and Invasion Ability against EPC Cells
2.7. The Role of preA in Environmental Stress of A. Veronii
2.8. Variation in the Expression of Oxidative Stress-Related Genes
3. Discussion
4. Materials and Methods
4.1. Bacterial Strains, Plasmids and Culture Conditions
4.2. Ethics Statement
4.3. Construction of A. veronii Deletion Mutant (∆preA) and Complemented Strain (C-preA)
4.4. Growth Analysis
4.5. Motility Test
4.6. Biofilm Assay
4.7. Pathogenicity Analysis
4.8. Adhesion and Invasion Ability
4.9. Cytotoxicity to EPC Cells
4.10. Stress Test
4.11. Expression of Oxidative Stress Related Gene
4.12. Statistical Analysis
5. Conclusions
Author Contributions
Funding
Acknowledgments
Conflicts of Interest
Abbreviations
| LB | Luria–Bertani |
| RS | Rimler–Shotts |
| EPC | Epithelioma papulosum cyprini |
| LDH | Lactate dehydrogenase |
| LD50 | Median lethal dose |
| qRT-PCR | Real-time quantitative reverse transcription-polymerase chain reaction |
| cDNA | Complementary DNA |
Appendix A
| Target Gene | Primer | Sequence (5′-3′) |
|---|---|---|
| preA upstream region | P1-1 (Xba I) | CGTCTAGAGCCGAGGTGACCGAGGCGACCATGG |
| P1-2 | GGAACTTCTGGCTGCTTCTTTGTACTGATTT | |
| preA downstream region | P1-3 | AAGAAGCAGCCAGAAGTTCCGCGCCCATT |
| P1-4 (Sac I) | TAGAGCTCCCGAGAGCTTGAGGGTGCCGT | |
| preA region outside | P3-1 | GCGCCATGGACGAAGTTGACC |
| P3-2 | ATCCGCAGCGCCAGATCGAA | |
| preA ORF internal sequence | P4-1 | AGGCCACACCCACCACAGGCT |
| P4-2 | CTGCAAACCCTGGCGGCTCC | |
| preA promoter sequence | P5-1 (Pst I) | AACTGCAGTTTCCATCCTCAGTAAATAATGA |
| P5-2 | TCAGTACAAACCGTTCGTTCCTTCATCTT | |
| preA ORF sequence | P6-1 | GAACGAACGGATGGGCGCGGAACTTCTGC |
| P6-2 (Hind III) | GCAAGCTTTCAGTACAAAGAAGCAGCAGGCC | |
| 16S rRNA sequence (used for qRT-PCR) | P7-1 | GCCACGTCTCAAGGACACAG |
| P7-2 | TGGGGAGCAAACAGGATTAGA | |
| preA ORF sequence (used for qRT-PCR) | P8-1 | TCTATGGCATACCGGAAAAGG |
| P8-2 | ACTGAACACCGCAAAGAGCA | |
| pRE112 vector | P9-1 | GCGATGAGTGGCAGGGC |
| P9-2 | TTACCGACTGCGGCCTGAGT | |
| pBBR1-MCS vector | P10-1 | TAAGTTGGGTAACGCCAGG |
| P10-2 | GAGTTAGCTCACTCATTAGGC |
| Target Gene | Primer | 5′-3′Sequence | Band Length (bp) |
|---|---|---|---|
| msrA | MsrA-F | GATTTCCACCCTCTTCATGCC | 156 |
| MsrA-R | AGCGGCGACTACCTCTGTGT | ||
| algW | AlgW-F | TGCGGGTGTAGATGTTGACG | 197 |
| AlgW-R | GAAAATCCCCCCTTTAGTCAGTTA | ||
| ibpA | IbpA-F | GCTTGTTGCCCTTCACCGT | 182 |
| IbpA-R | CGATCGTCTGGCCAATCTCAT | ||
| katA | KatA-F | TTCATCTCCCGCAGGCTCTT | 195 |
| KatA-R | CAACACCCCGGTCTTTTTCAT | ||
| HSP | HSP-F | TCGGCAATTCCCTGATGG | 189 |
| HSP-R | GAAGACCGCTGCTTACCCC | ||
| katB | KatB-F | TGAGCAATAATTCAGACAGTTCCG | 143 |
| KatB-R | CGGATTGGTCTTGGTATCGTGT |
References
- Parte, A.C. LPSN—List of prokaryotic names with standing in nomenclature. Nucleic Acids Res. 2013, 42, D613–D616. [Google Scholar] [CrossRef] [PubMed]
- Ghenghesh, K.S.; Abeid, S.S.; Jaber, M.M.; Ben-Taher, S.A. Isolation and haemolytic activity of Aeromonas species from domestic dogs and cats. Comp. Immunol. Microb. 1999, 22, 175–179. [Google Scholar] [CrossRef]
- D’Aloia, M.A.; Bailey, T.A.; Samour, J.H.; Naldo, J.; Howlett, J.C. Bacterial flora of captive houbara (Chlamydotis undulata), kori (Ardeotis kori) and rufous-crested (Eupodotis ruficrista) bustards. Avian Pathol. 1996, 25, 459–468. [Google Scholar] [CrossRef][Green Version]
- Zhang, D.X.; Kang, Y.H.; Song, M.F.; Shu, H.P.; Guo, S.N.; Jia, J.P.; Tao, L.T.; Zhao, Z.L.; Wang, C.F.; Wang, G.Q.; et al. Identity and virulence properties of Aeromonas isolates from healthy Northern snakehead (Channa argus) in China. Lett. Appl. Microbiol. 2019, 69, 100–109. [Google Scholar] [CrossRef] [PubMed]
- Yamada, S.; Matsushita, S.; Dejsirilert, S.; Kudoh, Y. Incidence and clinical symptoms of Aeromonas-associated travellers’ diarrhoea in Tokyo. Epidemiol. Infect. 1997, 119, 121–126. [Google Scholar] [CrossRef] [PubMed]
- Al Harbi, M.; Osoba, A.O.; Mowallad, A.; Al-Ahmadi, K. Tract microflora in Saudi patients with cholelithiasis. Trop. Med. Int. Health 2001, 6, 570–574. [Google Scholar] [CrossRef]
- Cascon, A.; Fregeneda, J.; Aller, M.; Yugueros, J.; Temprano, A.; Hernanz, C.; Naharro, G. Cloning, characterization, and insertional inactivation of a major extracellular serine protease gene with elastolytic activity from Aeromonas hydrophila. J. Fish Dis. 2000, 23, 49–59. [Google Scholar] [CrossRef]
- Stancik, L.M.; Stancik, D.M.; Schmidt, B.; Barnhart, D.M.; Yoncheva, Y.N.; Slonczewski, J.L. pH-dependent expression of periplasmic proteins and amino acid catabolism in Escherichia coli. J. Bacteriol. 2002, 184, 4246–4258. [Google Scholar] [CrossRef]
- Georgellis, D.; Arvidson, S.; Gabain, A.V. Decay of ompA mRNA and processing of 9S RNA are immediately affected by shifts in growth rate, but in opposite manners. J. Bacteriol. 1992, 174, 5382–5390. [Google Scholar] [CrossRef][Green Version]
- Lin, J.; Smith, M.P.; Chapin, K.C.; Baik, H.S.; Bennett, G.N.; Foster, J.W. Mechanisms of acid resistance in enterohemorrhagic Escherichia coli. Appl. Environ. Microb. 1996, 62, 3094–3100. [Google Scholar]
- Akashi, H.; Gojobori, T. Metabolic efficiency and amino acid composition in the proteomes of Escherichia coli and Bacillus subtilis. Proc. Natl. Acad. Sci. USA 2002, 99, 3695–3700. [Google Scholar] [CrossRef] [PubMed]
- Handa, N.; Terada, T.; Doi-Katayama, Y.; Hirota, H.; Tame, J.R.; Park, S.Y.; Yokoyama, S. Crystal structure of a novel polyisoprenoid-binding protein from Thermus thermophilus HB8. Protein Sci. 2005, 14, 1004–1010. [Google Scholar] [CrossRef] [PubMed]
- Flower, D.R. The lipocalin protein family: Structure and function. Biochem. J. 1996, 318, 1–14. [Google Scholar] [CrossRef] [PubMed]
- Collins, M.D.; Jones, D. Distribution of isoprenoid quinone structural types in bacteria and their taxonomic implication. Microbiol. Rev. 1981, 45, 316–354. [Google Scholar]
- Terwilliger, T.C. Automated side-chain model building and sequence assignment by template matching. Acta Cryst. D 2003, 59, 45–49. [Google Scholar] [CrossRef]
- Prüβ, B.M.; Wolfe, A.J. Regulation of acetyl phosphate synthesis and degradation, and the control of flagellar expression in Escherichia coli. Mol. Microbiol. 1994, 12, 973–984. [Google Scholar] [CrossRef]
- Soballe, R.; Poolle, R.K. Microbial ubiquinones: Multiple roles in respiration, gene regulation and oxidative stress management. Microbiol. 1999, 145, 1817–1830. [Google Scholar] [CrossRef]
- Daniels, D.L.; Plunkett, G.; Burland, V.; Blattner, F.R. Analysis of the Escherichia coli genome: DNA sequence of the region from 84.5 to 86.5 minutes. Science 1992, 257, 771–778. [Google Scholar] [CrossRef]
- Weber, A.; Kögl, S.A.; Jung, K. Time-dependent proteome alterations under osmotic stress during aerobic and anaerobic growth in Escherichia coli. J. Bacteriol. 2006, 188, 7165–7175. [Google Scholar] [CrossRef]
- Labandeira-Rey, M.; Brautigam, C.A.; Hansen, E.J. Characterization of the CpxRA regulon in Haemophilus ducreyi. Infect. Immun. 2010, 78, 4779–4791. [Google Scholar] [CrossRef]
- Kang, Y.H.; Pan, X.Y.; Xu, Y.; Siddiqui, S.A.; Wang, C.F.; Shan, X.F.; Qian, A.D. Complete genome sequence of the fish pathogen Aeromonas veronii TH0426 with potential application in biosynthesis of pullulanase and chitinase. J. Biotechnol. 2016, 227, 81–82. [Google Scholar] [CrossRef] [PubMed]
- Yang, B.T.; Zhang, D.X.; Wu, T.L.; Zhang, Z.Q.; Raza, S.H.; Schreurs, N.; Zhang, L.; Yang, G.L.; Wang, C.F.; Qian, A.D.; et al. Maltoporin (LamB protein) contributes to the virulence and adhesion of Aeromonas veronii TH0426. J. Fish Dis. 2019, 42, 379–389. [Google Scholar] [CrossRef] [PubMed]
- Zhou, Z.; Pang, H.; Ding, Y.; Cai, J.; Huang, Y.; Jian, J.; Wu, Z. VscO, a putative T3SS chaperone escort of Vibrio alginolyticus, contributes to virulence in fish and is a target for vaccine development. Fish Shellfish Immunol. 2013, 35, 1523–1531. [Google Scholar] [CrossRef]
- Rashid, M.H.; Kornberg, A. Inorganic polyphosphate is needed for swimming, swarming, and twitching motilities of Pseudomonas aeruginosa. Proc. Natl. Acad. Sci. USA 2000, 97, 4885–4890. [Google Scholar] [CrossRef] [PubMed]
- Stepanović, S.; Vuković, D.; Dakić, I.; Savić, B.; Švabić-Vlahović, M. A modified microtiter-plate test for quantification of staphylococcal biofilm formation. J. Microbiol. Methods. 2000, 40, 175–179. [Google Scholar] [CrossRef]
- Tu, J.; Lu, F.; Miao, S.; Ni, X.; Jiang, P.; Yu, H.; Hu, Q. The siderophore-interacting protein is involved in iron acquisition and virulence of Riemerella anatipestifer strain CH3. Vet. Microbiol. 2014, 168, 395–402. [Google Scholar] [CrossRef]
- Schwenteit, J.; Gram, L.; Nielsen, K.F.; Fridjonsson, O.H.; Bornscheuer, U.T.; Givskov, M.; Gudmundsdottir, B.K. Quorum sensing in Aeromonas salmonicida subsp. achromogenes and the effect of the autoinducer synthase AsaI on bacterial virulence. Vet. Microbiol. 2011, 147, 389–397. [Google Scholar] [CrossRef]
- Mathew, J.A.; Tan, Y.P.; Rao, P.S.S.; Lim, T.M.; Leung, K.Y. Edwardsiella tarda mutants defective in siderophore produciton, motility, serum resistance and catalase activity. Microbiology 2001, 147, 449–457. [Google Scholar] [CrossRef][Green Version]
- Fijan, N.; Sulimanović, D.; Bearzotti, M.; Muzinić, D.; Zwillenberg, L.O.; Chilmonczyk, S.; De Kinkelin, P. Some properties of the epithelioma papulosum cyprini (EPC) cell line from carp Cyprinus carpio. Ann. Inst. Pasteur/Virol. 1983, 134, 207–220. [Google Scholar] [CrossRef]
- Stintzi, A.; Raymond, K.N. Amonabactin-mediated iron acquisition from transferrin and lactoferrin by Aeromonas hydrophila: Direct measurement of individual microscopic rate constants. J. Biol. Inorg. Chem. 2000, 5, 57–66. [Google Scholar] [CrossRef]
- Lv, Y.; Xiao, J.; Liu, Q.; Wu, H.; Zhang, Y.; Wang, Q. Systematic mutation analysis of two-component signal transduction systems reveals EsrA-EsrB and PhoP-PhoQ as the major virulence regulators in Edwardsiella tarda. Vet. Microbiol. 2012, 157, 190–199. [Google Scholar] [CrossRef] [PubMed]
- Li, Q.; Zhang, Y.; Dechao, D.; Yanfei, Y.; Zhang, W. Characterization and functional analysis of PnuC that is involved in the oxidative stress tolerance and virulence of Streptococcus suis serotype 2. Vet. Microbiol. 2018, 216, 198–206. [Google Scholar] [CrossRef] [PubMed]

| Strains | Cytotoxicity a (%) | |
|---|---|---|
| 1 h | 2 h | |
| TH0426 | 23.1 ± 0.33 | 68.3 ± 0.71 |
| ∆preA | 33.4 ± 0.47 * | 86.7 ± 0.62 ** |
| C-preA | 22.5 ± 0.37 | 60.4 ± 0.42 |
| Strain | Number of Bacteria a (CFU/well) | Adhesion and Invasion to EPC (%) |
|---|---|---|
| TH0426 | (2.4 ± 0.16) × 107 | 16 ± 1.1 |
| ∆preA | (4.95 ± 0.05) × 107 | 33 ± 0.3 * |
| C-preA | (2.25 ± 0.08) × 107 | 15 ± 0.5 |
| Strains or Plasmids | Description | Source or References |
|---|---|---|
| Strains | ||
| A. veronii TH0426 | Wild-type strain, Ampr | This study |
| ∆preA | preA deletion mutant of TH0426, Ampr | This study |
| C-preA | ∆preA complemented with the whole preA gene | This study |
| E. coli Trans1-T1 | F- φ80(lacZ)ΔM15ΔlacX74hsdR (rk−, mk+) ΔrecA1398endA1tonA | TransGene Biotech |
| E. coli DH5α-λpir | λpir lysogen of DH5α | Stored in our lab |
| E. coli WM3064 | thrB1004 pro thi rpsL hsdS lacZ∆M15RP4-1360(araBAD)567∆dapA1341: [erm pir(wt)] | Stored in our lab |
| Plasmids | ||
| pEASY-Blunt Zero | TA cloning vector, Ampr | TransGene Biotech |
| pEASY-UD preA | Carrying a 1015 bp fragment upstream and a downstream 979 bp fragment of the preA ORF, Ampr | This study |
| pRE112 | pGP704 suicide plasmid, pir depengent, oriT, oriV, sacB, Cmr | Stored in our lab |
| pRE112-UDpreA | pRE112 carrying a 1015 bp fragment upstream and a downstream 979 bp fragment of the preA ORF, Cmr | This study |
| pBBR1-MCS | Broad-host range vector, Cmr | Stored in our lab |
| pBBR-preA | pBBR carrying a fragment of 847 bp containing the promoter and preA ORF, Cmr | This study |
© 2019 by the authors. Licensee MDPI, Basel, Switzerland. This article is an open access article distributed under the terms and conditions of the Creative Commons Attribution (CC BY) license (http://creativecommons.org/licenses/by/4.0/).
Share and Cite
Yang, B.; Song, H.; An, D.; Zhang, D.; Raza, S.H.A.; Wang, G.; Shan, X.; Qian, A.; Kang, Y.; Wang, C. Functional Analysis of preA in Aeromonas veronii TH0426 Reveals a Key Role in the Regulation of Virulence and Resistance to Oxidative Stress. Int. J. Mol. Sci. 2020, 21, 98. https://doi.org/10.3390/ijms21010098
Yang B, Song H, An D, Zhang D, Raza SHA, Wang G, Shan X, Qian A, Kang Y, Wang C. Functional Analysis of preA in Aeromonas veronii TH0426 Reveals a Key Role in the Regulation of Virulence and Resistance to Oxidative Stress. International Journal of Molecular Sciences. 2020; 21(1):98. https://doi.org/10.3390/ijms21010098
Chicago/Turabian StyleYang, Bintong, Haichao Song, Dingjie An, Dongxing Zhang, Sayed Haidar Abbas Raza, Guiqin Wang, Xiaofeng Shan, Aidong Qian, Yuanhuan Kang, and Chunfeng Wang. 2020. "Functional Analysis of preA in Aeromonas veronii TH0426 Reveals a Key Role in the Regulation of Virulence and Resistance to Oxidative Stress" International Journal of Molecular Sciences 21, no. 1: 98. https://doi.org/10.3390/ijms21010098
APA StyleYang, B., Song, H., An, D., Zhang, D., Raza, S. H. A., Wang, G., Shan, X., Qian, A., Kang, Y., & Wang, C. (2020). Functional Analysis of preA in Aeromonas veronii TH0426 Reveals a Key Role in the Regulation of Virulence and Resistance to Oxidative Stress. International Journal of Molecular Sciences, 21(1), 98. https://doi.org/10.3390/ijms21010098

